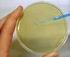
Materialanforderungen / Probenvorbereitung PRÄANALYTIK. Spezielle Materialerfordernisse (spezielle Bereiche); detaillierte Angaben einzelne Parameter

S-Monovette & Präanalytik
|
|
|
- Babette Katrin Kruse
- vor 8 Jahren
- Abrufe
Transkript
1 S-Monovette & Präanalytik
2 Kurzfristige Einflußgrößen Einfluß der Körperlage Anstieg der Konzentration beim Wechsel von liegender in die aufrechte Position: Parameter Anstieg in % Hämoglobin 5 % Leukocyten 7 % Hämatokrit 13 % Erythrocyten 15 % Calcium 5 % ASAT 6 % AP 6 % IgM 6 % Thyroxin 7 % IgG 7 % IgA 8 % Protein 9 % Triglyceride 9 % HDL-Cholesterin 10 % Aldosteron 15 % Epinephrine 48 % Renin 60 %
3 Einfluß der Stauzeit Vergleich 1 min. zu 3 min. Stauung: Parameter Abkürzung Veränderung in% Albumin Alb +3 alk. Phosphatase AP -2 Bilirubin BILI +8 Calcium CA +3 Chlorid CL -2 Cholesterol CHOL +5 Creatinin CREA -9 Creatinkinase CK -4 Eisen FE +7 Erythrocyten ERY +2 Glucose Gluc -9 y-glutamyltrans... Y-GT -10 Harnsäure HRS -4 Harnstoff HST -3 Kalium K -5 Lactatdehydrog... LDH -3 Lipase LIP +5 Phosphor P -7 Protein PROT +5 saure Phosphatase SP +3 Triglyceride TRIG -4
4 Vorbereitung des Patienten Informieren des Patienten - auf verständliche Weise - über die bevorstehende diagnostische Maßnahme und deren Sinn und Zweck, helfen Angst und Stress abzubauen. Erklärung über gewisse Vorschriften, die einzuhalten sind, sollten Patienteninformationen ergänzen, z.b. Einnahme von Arzneimitteln Einhaltung bestimmter Diäten Probennahme nüchtern ( außer Notfalldiagnostik ) zu der Verteilung von Sammelgefäßen für die Urin- oder Stuhlprobennahme gehören eindeutige Anweisungen für deren Handhabung besonders Kinder bedürfen einer behutsamen Vorbereitung, jedoch müssen die Informationen ihrem Begriffsvermögen angepasst sein
5 Identifikation der Probe Probengefäße ohne eindeutige Identifikation sollten niemals analysiert werden Barcode Etiketten sorgen auch hier für eine sichere Identifikation die Identifikation sollte stets auf dem Primärgefäß erfolgen für Glas oder Kunststoffgefäße nur wasserfeste Filzstifte verwenden eventuelle Zusätze (Gerinnungshemmer, Konservierungsmittel ) sind häufig durch einen Farbcode der Probengefäße gekennzeichnet. Aufgrund fehlender internationaler Standardisierung ist ggf. zusätzliche Kennzeichnung erforderlich Identifikation der Probe nie auf Deckel, Umverpackung oder Transportbehälter durchführen
6 Identifikation der Probe Barcode Etiketten sorgen für eine sichere Identifikation der Probe
7 Identifikation der Probe Probengefäße sind richtig etikettiert wenn: - eine freie Sicht auf den Inhalt gewährleistet ist - die Kontrolle des Füllstandes möglich ist - der Stopfen ungehindert zu entfernen ist - Röhrchen und Etikett sich in der Zentrifuge nicht verklemmen oder verkleben Infektiöses Material auf dem Röhrchen und dem Anforderungsbeleg deutlich kennzeichnen
8 Identifikation des anfordernden Arztes Identität des anfordernden Arztes ermöglicht Rückfragen bei unleserlichen Anforderungen falschen Anforderungen (z.b. Prostataphosphatase bei einer weiblichen Patientin) Eingrenzung auf wichtigste Analysen bei zu geringem Probenmaterial
9 Gewinnung des Untersuchungsmaterials Entnahmestellen: Grundsätzlich alle oberflächlich liegende Venen - der Ellenbeuge - des Unterarms - des Handrückens
10 Venenstauung Durchführung: Anlegen des Stauschlauchs eine Handbreite proximal von der Punktionsstelle Lage, Verlauf und Beschaffenheit der Vene prüfen Puls muss fühlbar sein (Staudruck mm Hg) Desinfektion der anvisierten Punktionsstelle mit 70 % Isopropanol Nach Sekunden Einwirkzeit mit trockenem unsterilen Tupfer abwischen Stauzeit 1 min. sollte nicht überschritten werden
11 S-Monovette Handhabungshinweis Aspirationstechnik Kanüle der S-Monovette durch leichtes Drehen im Uhrzeigersinn arretieren Vene punktieren, durch langsames Zurückziehen der Kolbenstange erfolgt der Blutstrom Lösen der S-Monovette durch leichtes Drehen gegen den Uhrzeigersinn. Danach Kanüle aus der Vene ziehen. Für Transport und Zentrifugation Kolbenstange in den Knack ziehen und abbrechen.
12 S-Monovette Handhabungshinweis aufrecht stehend geronnen liegend geronnene Probe
13 S-Monovette Anwendungsbereiche Präparierung Anwendungsbereich Serum Serum Gel Lithium Heparin EDTA Citrat 1:10 Citrat 1:5 Fluorid Klinische Chemie, Serologie, Spezialuntersuchungen Klinische Chemie, Serologie ( nur Routinediagnostik ) Plasmagewinnung für klin.chemie, Serologie (kein Li. Und Elpho ) Hämatologie ( z.b. Hb,HK,Erys,Leucos, ) Gerinnungsanalytik (z.b. Quick,PTT,TZ,Fibrinogen) BSG Bestimmung nach Westergren bzw. Sedivette Glukosebestimmung (stabil 24Std.) sowie enzym. Lactat
14 S-Monovette Monovette Farbcode Europäischer Farbcode Päparierung Serum Amerikanischer Farbcode Serum-Gel Lithium-Heparin Glukose EDTA K Citrat BSG (1:5) Citrat Gerinnung (1:10)
15 Entnahmereihenfolge Blutkultur Nativblut Citratblut Heparinblut EDTA Blut Fluoridblut ( Empfehlung aus: Proben zwischen Patient und Labor") GIT VERLAG
16 Aufbewahrung und Transport der Probe Blutproben so rasch als möglich ins Labor bringen und analysieren als Diffusionsbarrieren verhindern nach Zentrifugation Trenngele oder Filter eine Diffusion von Stoffen aus den Erythrocyten in das Serum/ Plasma Serum oder Plasma, das nicht von den Erythrocyten ( Vollblut ) abgetrennt wurde, darf auf keinen Falltiefgefroren werden. Eine völlige Hämolyse wäre die Folge
17 Einfluss von Temperatur und Zeit Glukose m g/dl Stunden aus: Proben zwischen Patient und Labor W.G. Guder Lagertemperatur: o = 30 C o = 23 C o = 4 C GIT Verlag
18 Einfluss von Temperatur und Zeit Kalium mmol/l Stunden Lagertemperatur: o = 30 C o = 23 C o = 4 C aus: Proben zwischen Patient und Labor W.G. Guder GIT Verlag
19 Präanalytik Fehler bei der Präanalytik sind die Stellen vor dem Komma Fehler bei der Laboranalytik sind die Stellen nach dem Komma
Vorbereitung des Patienten
 Vorbereitung des Patienten Informieren des Patienten auf verständliche Weise - über die bevorstehenden diagnostischen Maßnahmen und deren Sinn und Zweck, helfen Angst und Stress abzubauen. Erklärungen
Vorbereitung des Patienten Informieren des Patienten auf verständliche Weise - über die bevorstehenden diagnostischen Maßnahmen und deren Sinn und Zweck, helfen Angst und Stress abzubauen. Erklärungen
_ED_Anhang.qxd :38 Seite 1557 Anhang Appendix
 Anhang Appendix Maße und Gewichte Weights and Measures Anhang Appendix I. Längenmaße I. Linear Measures 1. Amerikanische Längenmaße 1. American Linear Measure 1 yard = 3 feet = 0,9144 m = 91,44 cm 1 foot
Anhang Appendix Maße und Gewichte Weights and Measures Anhang Appendix I. Längenmaße I. Linear Measures 1. Amerikanische Längenmaße 1. American Linear Measure 1 yard = 3 feet = 0,9144 m = 91,44 cm 1 foot
Anlage zur Akkreditierungsurkunde D ML 13260 01 00
 Deutsche Akkreditierungsstelle GmbH Anlage zur Akkreditierungsurkunde D ML 13260 01 00 nach DIN EN ISO 15189:2007 Gültigkeitsdauer: 09.10.2012 bis 08.10.2017 Urkundeninhaber: Arbeitsgemeinschaft Ostwestfälischer
Deutsche Akkreditierungsstelle GmbH Anlage zur Akkreditierungsurkunde D ML 13260 01 00 nach DIN EN ISO 15189:2007 Gültigkeitsdauer: 09.10.2012 bis 08.10.2017 Urkundeninhaber: Arbeitsgemeinschaft Ostwestfälischer
Allgemeine Klinische Chemie und Präanalytik 1
 Allgemeine Klinische Chemie und Präanalytik 1 Frage 1: 1 Punkt Hämolyse stört die Bestimmung folgender klinisch-chemischer Kenngröße am wenigsten: a. Kalium b. Glukose c. Eisen d. LDH e. GOT = ASAT Frage
Allgemeine Klinische Chemie und Präanalytik 1 Frage 1: 1 Punkt Hämolyse stört die Bestimmung folgender klinisch-chemischer Kenngröße am wenigsten: a. Kalium b. Glukose c. Eisen d. LDH e. GOT = ASAT Frage
Klinische Chemie Praxis 10. Kursblock, KW 14: Überprüfung der Ziele Block 2
 Klinische Chemie Praxis 10. Kursblock, KW 14: Überprüfung der Ziele Block 2 1. Harndiagnostik: 1.) Eine Patientin hat einen Pilzinfekt was sehen Sie im Urinsediment und wo gibt der Stix positiv an? 2.)
Klinische Chemie Praxis 10. Kursblock, KW 14: Überprüfung der Ziele Block 2 1. Harndiagnostik: 1.) Eine Patientin hat einen Pilzinfekt was sehen Sie im Urinsediment und wo gibt der Stix positiv an? 2.)
Tipps & Tricks in der Präanalytik
 Tipps & Tricks in der Präanalytik Präanalytik & S-Monovette Die Grundvoraussetzung für eine präzise und aussagefähige Labordiagnostik ist eine optimale Präanalytik. Die Laborwerte können nur dann korrekt
Tipps & Tricks in der Präanalytik Präanalytik & S-Monovette Die Grundvoraussetzung für eine präzise und aussagefähige Labordiagnostik ist eine optimale Präanalytik. Die Laborwerte können nur dann korrekt
Zur Registrierung der Proben sind folgende Angaben auf dem Auftragsschein wichtig:
 Probentransport Zur Registrierung der Proben sind folgende Angaben auf dem Auftragsschein wichtig: Datum der Probenentnahme Uhrzeit der Probenentnahme Vollständige Patientendaten (Name, Vorname, Geburtsdatum
Probentransport Zur Registrierung der Proben sind folgende Angaben auf dem Auftragsschein wichtig: Datum der Probenentnahme Uhrzeit der Probenentnahme Vollständige Patientendaten (Name, Vorname, Geburtsdatum
Präanalytik venöse Blutentnahme. Monika Hegen-Tytgat
 Präanalytik venöse Blutentnahme Monika Hegen-Tytgat Das Blut - In vivo Welche Angabe ist korrekt? Die Gesamtlänge aller Blutgefäße beträgt ca. 0,5 km 10 km 500 km 5 000 km 10 000 km 90 000 km 2 Das Blut
Präanalytik venöse Blutentnahme Monika Hegen-Tytgat Das Blut - In vivo Welche Angabe ist korrekt? Die Gesamtlänge aller Blutgefäße beträgt ca. 0,5 km 10 km 500 km 5 000 km 10 000 km 90 000 km 2 Das Blut
Richtwerte Laborgemeinschaft Stand:
 Richtwerte Laborgemeschaft Stand: 01.09.2016 Album ALBUML ALBUM Erwachsene m/w 55,8 66,1 % Kder m/w 4 Wochen 56,3 78.0 % m/w 1 Jahr 56,5 81,2 % m/w 14 Jahre 53,9 77,3 % Alkal.Phosphatase AP-L AP Erwachsene
Richtwerte Laborgemeschaft Stand: 01.09.2016 Album ALBUML ALBUM Erwachsene m/w 55,8 66,1 % Kder m/w 4 Wochen 56,3 78.0 % m/w 1 Jahr 56,5 81,2 % m/w 14 Jahre 53,9 77,3 % Alkal.Phosphatase AP-L AP Erwachsene
Reflotron System. Präsenzdiagnostik für jeden Patienten wertvoll
 Reflotron System Präsenzdiagnostik für jeden Patienten wertvoll Das bewährte System für die klinische Chemie Zuverlässige Bestimmung von 17 Parametern in Ihrer Praxis Das Reflotron System ist ein Einzeltestsystem
Reflotron System Präsenzdiagnostik für jeden Patienten wertvoll Das bewährte System für die klinische Chemie Zuverlässige Bestimmung von 17 Parametern in Ihrer Praxis Das Reflotron System ist ein Einzeltestsystem
Leistungsverzeichnis. nach Validation über KAS und / oder Netzdruck bzw. Fax
 Seite 1 von 7 1. Klinische Indikation Analyt: - Allgemeines Screening Kleines Blutbild - Anämie-, Leukämiediagnostik und andere hämatologische Fragestellungen - Infektdiagnostik - Verlaufsbeurteilung und
Seite 1 von 7 1. Klinische Indikation Analyt: - Allgemeines Screening Kleines Blutbild - Anämie-, Leukämiediagnostik und andere hämatologische Fragestellungen - Infektdiagnostik - Verlaufsbeurteilung und
Anlage zur Akkreditierungsurkunde D-ML-13198-01-00 nach DIN EN ISO 15189:2014
 Deutsche Akkreditierungsstelle GmbH Anlage zur Akkreditierungsurkunde D-ML-13198-01-00 nach DIN EN ISO 15189:2014 Gültigkeitsdauer: 27.05.2015 bis 04.02.2019 Ausstellungsdatum: 27.05.2015 Urkundeninhaber:
Deutsche Akkreditierungsstelle GmbH Anlage zur Akkreditierungsurkunde D-ML-13198-01-00 nach DIN EN ISO 15189:2014 Gültigkeitsdauer: 27.05.2015 bis 04.02.2019 Ausstellungsdatum: 27.05.2015 Urkundeninhaber:
Anlage zur Akkreditierungsurkunde D-ML nach DIN EN ISO 15189:2014
 Deutsche Akkreditierungsstelle GmbH Anlage zur Akkreditierungsurkunde D-ML-13347-01-02 nach DIN EN ISO 15189:2014 Gültigkeitsdauer: 28.10.2015 bis 27.10.2020 Ausstellungsdatum: 28.10.2015 Urkundeninhaber:
Deutsche Akkreditierungsstelle GmbH Anlage zur Akkreditierungsurkunde D-ML-13347-01-02 nach DIN EN ISO 15189:2014 Gültigkeitsdauer: 28.10.2015 bis 27.10.2020 Ausstellungsdatum: 28.10.2015 Urkundeninhaber:
Laboranalysen. Angebot
 Laboranalysen Angebot Was bietet Ihnen das Walk-in Labor? Im Walk-in Labor können Sie gegen Barbezahlung kostengünstige Blut- und Urinuntersuchungen aus unserem Analysenkatalog machen lassen. > Unkompliziert
Laboranalysen Angebot Was bietet Ihnen das Walk-in Labor? Im Walk-in Labor können Sie gegen Barbezahlung kostengünstige Blut- und Urinuntersuchungen aus unserem Analysenkatalog machen lassen. > Unkompliziert
Prüfungsfragenkatalog für Diagnostik (Prof. Astrid Ortner)
 Prüfungsfragenkatalog für Diagnostik (Prof. Astrid Ortner) Stand: Dezember 2016 Termin: 15.12.2016 1. POCT-Systeme: Definition, Beispiele, Vorteile, Begriffserklärung 2. Leberdiagnostik GGT: Wann wird
Prüfungsfragenkatalog für Diagnostik (Prof. Astrid Ortner) Stand: Dezember 2016 Termin: 15.12.2016 1. POCT-Systeme: Definition, Beispiele, Vorteile, Begriffserklärung 2. Leberdiagnostik GGT: Wann wird
Sie möchten gegen Barbezahlung kostengünstige Analysen aus unserem Analysenkatalog machen lassen
 www.walkin3.ch I 043 434 81 40 analysenangebot Was bietet Ihnen das WALK-IN Labor? Sie möchten gegen Barbezahlung kostengünstige Analysen aus unserem Analysenkatalog machen lassen Unkompliziert - einfach
www.walkin3.ch I 043 434 81 40 analysenangebot Was bietet Ihnen das WALK-IN Labor? Sie möchten gegen Barbezahlung kostengünstige Analysen aus unserem Analysenkatalog machen lassen Unkompliziert - einfach
Klinisches Institut für Medizinische und Chemische Labordiagnostik (KIMCL) Allgemeines Krankenhaus Wien. Medizinische Universität Wien
 Klinisches Institut für Medizinische und Chemische Labordiagnostik (KIMCL) Allgemeines Krankenhaus Wien Medizinische Universität Wien KlMCL Probenaufkommen Ca. 8.000 Proben/Tag Ca. 80.000 Ergebnisse/ Tag
Klinisches Institut für Medizinische und Chemische Labordiagnostik (KIMCL) Allgemeines Krankenhaus Wien Medizinische Universität Wien KlMCL Probenaufkommen Ca. 8.000 Proben/Tag Ca. 80.000 Ergebnisse/ Tag
Praxis der Klinisch-chemischen Labordiagnostik Klinische Chemie
 Praxis der Klinisch-chemischen Labordiagnostik Klinische Chemie Die Anwendung chemischer, molekularer und zellulärer (einschl. Hämatologie und Gerinnung) Strategien und Techniken für das Verständnis und
Praxis der Klinisch-chemischen Labordiagnostik Klinische Chemie Die Anwendung chemischer, molekularer und zellulärer (einschl. Hämatologie und Gerinnung) Strategien und Techniken für das Verständnis und
Zertifikat. Januar 2005. ( Gültigkeitsdauer 6 Monate) Chlorid (M.7) (R) Kupfer (M.2) Albumin (M.I) (R) Glucose (M.I) (R)
 ( Gültigkeitsdauer 6 Monate) INSTAND e.v. Institut für Standardisierung und Ubier - Str. 2 / PF 25211 4223 / 493 Düsseldorf Tel. (211) 159213 - FAX (211) 159213-3 Der unten genannte Teilnehmer hat die
( Gültigkeitsdauer 6 Monate) INSTAND e.v. Institut für Standardisierung und Ubier - Str. 2 / PF 25211 4223 / 493 Düsseldorf Tel. (211) 159213 - FAX (211) 159213-3 Der unten genannte Teilnehmer hat die
Pro richtige Zeile 1 Punkt Übertrag 5
 Hygiene, Arbeitssicherheit, Umweltschutz Anzahl Punkte Aufgabe 1 Geben Sie an, wie die folgenden, gebrauchten Materialien entsorgt werden müssen: Abfall: Entsorgung: Monovetten-Kanüle Urinbecher Objektträger
Hygiene, Arbeitssicherheit, Umweltschutz Anzahl Punkte Aufgabe 1 Geben Sie an, wie die folgenden, gebrauchten Materialien entsorgt werden müssen: Abfall: Entsorgung: Monovetten-Kanüle Urinbecher Objektträger
zise Analytik als im Labor. Die POCT steht im Spannungsfeld zwischen Arzt, Labor und Diagnostika-Industrie.
 8 Allgemeine Klinische Chemie zise Analytik als im Labor. Die POCT steht im Spannungsfeld zwischen Arzt, Labor und Diagnostika-Industrie. Funktionstests wurden früher häufig in der Organdiagnostik (z.
8 Allgemeine Klinische Chemie zise Analytik als im Labor. Die POCT steht im Spannungsfeld zwischen Arzt, Labor und Diagnostika-Industrie. Funktionstests wurden früher häufig in der Organdiagnostik (z.
Vom Patienten zur Analysenprobe Präanalytik für die klinische Chemie, Gerinnung und Hämatologie
 Vom Patienten zur Analysenprobe Präanalytik für die klinische Chemie, Gerinnung und Hämatologie Die korrekte Vorbereitung des Patienten, die richtige Blutentnahme, die Benutzung der richtigen Abnahmegefäße
Vom Patienten zur Analysenprobe Präanalytik für die klinische Chemie, Gerinnung und Hämatologie Die korrekte Vorbereitung des Patienten, die richtige Blutentnahme, die Benutzung der richtigen Abnahmegefäße
Anlage zur Akkreditierungsurkunde D-ML-13446-01-00 nach DIN EN ISO 15189:2007
 Deutsche Akkreditierungsstelle GmbH Anlage zur Akkreditierungsurkunde D-ML-13446-01-00 nach DIN EN ISO 15189:2007 Gültigkeitsdauer: 08.05.2014 bis 24.07.2017 Ausstellungsdatum: 08.05.2014 Urkundeninhaber:
Deutsche Akkreditierungsstelle GmbH Anlage zur Akkreditierungsurkunde D-ML-13446-01-00 nach DIN EN ISO 15189:2007 Gültigkeitsdauer: 08.05.2014 bis 24.07.2017 Ausstellungsdatum: 08.05.2014 Urkundeninhaber:
lehmanns Labordiagnostische Referenzwerte in der Tiermedizin
 lehmanns m e d i a In Kooperation mit Labordiagnostische Referenzwerte in der Tiermedizin Großtier: Pferd, Rind, Schwein, Schaf, Ziege Kleintier: Hund, Katze Heimtier: Kaninchen, Meerschweinchen, Frettchen,
lehmanns m e d i a In Kooperation mit Labordiagnostische Referenzwerte in der Tiermedizin Großtier: Pferd, Rind, Schwein, Schaf, Ziege Kleintier: Hund, Katze Heimtier: Kaninchen, Meerschweinchen, Frettchen,
Zertifikat. Ringversuch August 2005. Gültigkeitsdauer 12 Monate (R)= RiliBÄK: Gültigkeitsdauer6 Monate
 1 145 161 241 292 7 BI. 51 Rv=55, Crvz/Lzert 29,9,25 DAC Duplikat Ringversuch August 25 Ubier - Str. 2 I PF 25211 4223 I 493 Düsseldorf Tel. (211) 159213 - FAX (211) 159213-3 Der unten genannte Teilnehmer
1 145 161 241 292 7 BI. 51 Rv=55, Crvz/Lzert 29,9,25 DAC Duplikat Ringversuch August 25 Ubier - Str. 2 I PF 25211 4223 I 493 Düsseldorf Tel. (211) 159213 - FAX (211) 159213-3 Der unten genannte Teilnehmer
Immunglobulin-E (IgE), quantitativ
 Immunelektrophorese einschließlich Immunglobuline quantitativ Erwachsene: 0,7 3,8 g/l 2 5 Jahre: 0,5 1,0 g/l 6 10 Jahre: 0,7 2,1 g/l 11 18 Jahre: 0,8 2,2 g/l Immunglobulin-A (IgA) 0,2 0,6 mg/dl 1 ml Liquor
Immunelektrophorese einschließlich Immunglobuline quantitativ Erwachsene: 0,7 3,8 g/l 2 5 Jahre: 0,5 1,0 g/l 6 10 Jahre: 0,7 2,1 g/l 11 18 Jahre: 0,8 2,2 g/l Immunglobulin-A (IgA) 0,2 0,6 mg/dl 1 ml Liquor
Liquor- und Punktatdiagnostik Inhaltsverzeichnis
 Inhaltsverzeichnis Liquordiagnostik...2 Albumin...2 Chlorid...2 Gesamteiweiß...2 Glucose...2 Immunglobulin A...2 Immunglobulin G...2 Immunglobulin M...2 Lactat...2 NSE...3 TPHA...3 Zellzahl / Zellart...3
Inhaltsverzeichnis Liquordiagnostik...2 Albumin...2 Chlorid...2 Gesamteiweiß...2 Glucose...2 Immunglobulin A...2 Immunglobulin G...2 Immunglobulin M...2 Lactat...2 NSE...3 TPHA...3 Zellzahl / Zellart...3
Walk-in Laboranalysen
 Walk-in Laboranalysen Zypressenstrasse 41 8003 Zürich Telefon 043 434 81 40 [email protected] www.walkin-labor.ch Öffnungszeiten Mo bis Fr 8 19 Uhr Sa 10 14 Uhr Albisriederstrasse Badenerstrasse Badenerstrasse
Walk-in Laboranalysen Zypressenstrasse 41 8003 Zürich Telefon 043 434 81 40 [email protected] www.walkin-labor.ch Öffnungszeiten Mo bis Fr 8 19 Uhr Sa 10 14 Uhr Albisriederstrasse Badenerstrasse Badenerstrasse
Anlage zur Akkreditierungsurkunde D-ML-18008-01-00 nach DIN EN ISO 15189:2007
 Deutsche Akkreditierungsstelle GmbH Anlage zur Akkreditierungsurkunde D-ML-18008-01-00 nach DIN EN ISO 15189:2007 Gültigkeitsdauer: 21.09.2012 bis 20.09.2017 Urkundeninhaber: Medizinisches Versorgungszentrum
Deutsche Akkreditierungsstelle GmbH Anlage zur Akkreditierungsurkunde D-ML-18008-01-00 nach DIN EN ISO 15189:2007 Gültigkeitsdauer: 21.09.2012 bis 20.09.2017 Urkundeninhaber: Medizinisches Versorgungszentrum
KLINISCHE CHEMIE / SONDERPARAMETER ALAT (GPT)
 KLINISCHE CHEMIE / SONDERPARAMETER ALAT (GPT) 0-0,84 0-0,59 µmol/s*l 0-50,4 0-35 U/l Amylase 30-90 30-90 U/l 30-90 30-90 U/l Ammoniak 14,7-55,3 11,2-48,2 µmol/l Anti-Streptolysin-Titer (AST) quant. 200
KLINISCHE CHEMIE / SONDERPARAMETER ALAT (GPT) 0-0,84 0-0,59 µmol/s*l 0-50,4 0-35 U/l Amylase 30-90 30-90 U/l 30-90 30-90 U/l Ammoniak 14,7-55,3 11,2-48,2 µmol/l Anti-Streptolysin-Titer (AST) quant. 200
Präanalytische Fehler am Beispiel der Hämolyse und die daraus entstehenden Kosten
 Präanalytische Fehler am Beispiel der Hämolyse und die daraus entstehenden Kosten Dr. Silke Zeipert-Böckle Datum: 09.05.2012 Gliederung Präanalytische Fehler Präanalytik Warum so wichtig? Präanalytische
Präanalytische Fehler am Beispiel der Hämolyse und die daraus entstehenden Kosten Dr. Silke Zeipert-Böckle Datum: 09.05.2012 Gliederung Präanalytische Fehler Präanalytik Warum so wichtig? Präanalytische
x75 Gerinnungsaktivator PET Papier Hemogard durchsichtig rot x75 Gerinnungsaktivator PET ohne Hemogard durchsichtig rot
 in Serum-Kunststoffröhrchen Um Serum in Blutentnahmeröhrchen aus Kunststoff zu gewinnen, muss den Röhrchen ein zugesetzt werden. Da die Kunststoffoberfläche allein nicht ausreicht, um die Gerinnung innerhalb
in Serum-Kunststoffröhrchen Um Serum in Blutentnahmeröhrchen aus Kunststoff zu gewinnen, muss den Röhrchen ein zugesetzt werden. Da die Kunststoffoberfläche allein nicht ausreicht, um die Gerinnung innerhalb
cobas c 111 analyzer Das kompakte Analysensystem für die klinische Chemie
 cobas c 111 analyzer Das kompakte Analysensystem für die klinische Chemie cobas T Systemfamilie Die richtige Lösung für jede Laborgröße Jedes Labor ist einzigartig. Die Bandbreite der Tests, Anzahl der
cobas c 111 analyzer Das kompakte Analysensystem für die klinische Chemie cobas T Systemfamilie Die richtige Lösung für jede Laborgröße Jedes Labor ist einzigartig. Die Bandbreite der Tests, Anzahl der
SPTS Datum des ersten Ringversuchs 1972 Anzahl Teilnehmer (2016) Chemie: Ammonium: 75 CKMB: 35 CRP: HbA1c: Bili NG: 95
 SPTS 0004 KLINISCHE CHEMIE Services suisses d'essais d aptitude Schweizerische Eignungsprüfungsdienststellen Servizi svizzeri di prove valutative interlaboratorio Swiss proficiency testing services Charakteristika
SPTS 0004 KLINISCHE CHEMIE Services suisses d'essais d aptitude Schweizerische Eignungsprüfungsdienststellen Servizi svizzeri di prove valutative interlaboratorio Swiss proficiency testing services Charakteristika
Hämatologie und klinische Chemie. Praeanalytik. Nur eine korrekt entnommene Blutprobe ermöglicht eine aussagekräftige Laboruntersuchung
 Hämatologie und klinische Chemie Praeanalytik Nur eine korrekt entnommene Blutprobe ermöglicht eine aussagekräftige Laboruntersuchung (Rubbish in Rubbish out) Einleitung Unter Präanalytik werden die Einflussgrössen
Hämatologie und klinische Chemie Praeanalytik Nur eine korrekt entnommene Blutprobe ermöglicht eine aussagekräftige Laboruntersuchung (Rubbish in Rubbish out) Einleitung Unter Präanalytik werden die Einflussgrössen
Präanalytik. Ohne gute Präanalytik - kein guter Laborbefund!
 Präanalytik Ohne gute Präanalytik - kein guter Laborbefund! Fragestellung Testauswahl Anforderung Patientenidentifikation Probennahme Probentransport 1. präanalytische Phase außerhalb des Labors 2. präanalytische
Präanalytik Ohne gute Präanalytik - kein guter Laborbefund! Fragestellung Testauswahl Anforderung Patientenidentifikation Probennahme Probentransport 1. präanalytische Phase außerhalb des Labors 2. präanalytische
Einfluss von Störfaktoren auf Messgrössen Präanalytik II
 Einfluss von Störfaktoren auf Messgrössen Präanalytik II Einleitung Die Präanalytik umfasst alle Arbeitsschritte, welche vor der eigentlichen Laboranalyse liegen (Probenentnahme, Probentransport, Probenlagerung).
Einfluss von Störfaktoren auf Messgrössen Präanalytik II Einleitung Die Präanalytik umfasst alle Arbeitsschritte, welche vor der eigentlichen Laboranalyse liegen (Probenentnahme, Probentransport, Probenlagerung).
Blutabnahme. Workshop mit Übungen für ArztassistentInnen. Univ. Doz. Georg Endler & Sonja Meyer
 Herzlich Willkommen www.ordibed.at Blutabnahme Workshop mit Übungen für ArztassistentInnen Univ. Doz. Georg Endler & Sonja Meyer Die nächsten 45 Minuten Rechtliche Grundlagen Welches Röhrchen wofür? Technische
Herzlich Willkommen www.ordibed.at Blutabnahme Workshop mit Übungen für ArztassistentInnen Univ. Doz. Georg Endler & Sonja Meyer Die nächsten 45 Minuten Rechtliche Grundlagen Welches Röhrchen wofür? Technische
DR. LÖER DR. TREDER UND KOLLEGEN PRÄANALYTIK. Herausgeben von. Hans Peter Seelig
 DR. LÖER DR. TREDER UND KOLLEGEN PRÄANALYTIK Herausgeben von Hans Peter Seelig Autoren: Prof. Dr. med. Hans Peter Seelig Dr. rer. nat. Thomas Stauch Dr. med. J. O. Schurek Labor Prof. Seelig und Kollegen
DR. LÖER DR. TREDER UND KOLLEGEN PRÄANALYTIK Herausgeben von Hans Peter Seelig Autoren: Prof. Dr. med. Hans Peter Seelig Dr. rer. nat. Thomas Stauch Dr. med. J. O. Schurek Labor Prof. Seelig und Kollegen
Was ist Normal? - Interpretation von Referenzintervallen. Oswald Sonntag, Bio-Rad Laboratories GmbH
 Was ist Normal? - Interpretation von Referenzintervallen Oswald Sonntag, Bio-Rad Laboratories GmbH Definition Normalbereich (-wert) Referenzbereich (-wert, -intervall) Erwarteter Wert Alterseinteilung
Was ist Normal? - Interpretation von Referenzintervallen Oswald Sonntag, Bio-Rad Laboratories GmbH Definition Normalbereich (-wert) Referenzbereich (-wert, -intervall) Erwarteter Wert Alterseinteilung
Präanalytik-Handbuch (Kurzform)
 Präanalytik-Handbuch (Kurzform) inkl. Dokument für die Gewinnung des Untersuchungsmaterials gemäß Richtline der Bundesärztekammer zur Qualitätssicherung laboratoriumsmedizinischer Untersuchungen Version
Präanalytik-Handbuch (Kurzform) inkl. Dokument für die Gewinnung des Untersuchungsmaterials gemäß Richtline der Bundesärztekammer zur Qualitätssicherung laboratoriumsmedizinischer Untersuchungen Version
Anlage zur Akkreditierungsurkunde D-ML-18208-01-00 nach DIN EN ISO 15189:2013
 Deutsche Akkreditierungsstelle GmbH Anlage zur Akkreditierungsurkunde D-ML-18208-01-00 nach DIN EN ISO 15189:2013 Gültigkeitsdauer: 17.07.2014 bis 16.07.2019 Ausstellungsdatum: 17.07.2014 Urkundeninhaber:
Deutsche Akkreditierungsstelle GmbH Anlage zur Akkreditierungsurkunde D-ML-18208-01-00 nach DIN EN ISO 15189:2013 Gültigkeitsdauer: 17.07.2014 bis 16.07.2019 Ausstellungsdatum: 17.07.2014 Urkundeninhaber:
Analysenverzeichnis 2012
 Analysenverzeichnis 2012 Allgemeine Informationen Probenkennzeichnung Bitte beschriften Sie zur Sicherung der Identität das Probenröhrchen mit Vor- und Zuname des Patienten, Geburtsdatum, Abnahmedatum,
Analysenverzeichnis 2012 Allgemeine Informationen Probenkennzeichnung Bitte beschriften Sie zur Sicherung der Identität das Probenröhrchen mit Vor- und Zuname des Patienten, Geburtsdatum, Abnahmedatum,
Klinische Chemie, Proteinchemie. Häufigkeit; Weiterleitung Kommentar. Referenz- Bereich. Analyt Material Alter
 Aethanol Serum,HepPl Erw. < 0,1 g/l PHOT täglich Umrechnung in Promille : Alkohol (g/l) x 0,81 Albumin Serum, Hep.Pl < 1J 30-42 g/l PHOT täglich > 1J 35-55 g/l Punktat Erw. < 150 mg/l PHOT täglich Alkalische
Aethanol Serum,HepPl Erw. < 0,1 g/l PHOT täglich Umrechnung in Promille : Alkohol (g/l) x 0,81 Albumin Serum, Hep.Pl < 1J 30-42 g/l PHOT täglich > 1J 35-55 g/l Punktat Erw. < 150 mg/l PHOT täglich Alkalische
Ein Lei'aden für medizinisches Assistenzpersonal DR. MED. JÖRG- R. KRONE. Laborproben Präanaly.k & Logis.k Hämatologie und klinische Chemie
 Ein Lei'aden für medizinisches Assistenzpersonal DR. MED. JÖRG- R. KRONE Laborproben Präanaly.k & Logis.k Hämatologie und klinische Chemie Dr.med. Jörg- R. Krone POSTULAT Eine präzise Diagnose ist Grundlage
Ein Lei'aden für medizinisches Assistenzpersonal DR. MED. JÖRG- R. KRONE Laborproben Präanaly.k & Logis.k Hämatologie und klinische Chemie Dr.med. Jörg- R. Krone POSTULAT Eine präzise Diagnose ist Grundlage
Variablen-Übersicht der Patientenkohorte (Erwachsene) des Kompetenznetzes HIV/AIDS
 Variablen-Übersicht der Patientenkohorte (Erwachsene) des Kompetenznetzes HIV/AIDS Stand: Juli 2008 Variablen-Übersicht Patientenkohorte 2 Inhalt I. Soziodemographie... 3 II. Anamnese... 3 II.1. Familienanamnese...
Variablen-Übersicht der Patientenkohorte (Erwachsene) des Kompetenznetzes HIV/AIDS Stand: Juli 2008 Variablen-Übersicht Patientenkohorte 2 Inhalt I. Soziodemographie... 3 II. Anamnese... 3 II.1. Familienanamnese...
EMPFINDLICHE UNTERSUCHUNGSPARAMETER
 Die folgende Liste enthält die häufigsten Untersuchungsparameter, bei denen eine besondere Probenbehandlung (z.b. Kühlung) erforderlich ist, um optimale Ergebnisse zu erhalten. Da hier nicht alle Parameter
Die folgende Liste enthält die häufigsten Untersuchungsparameter, bei denen eine besondere Probenbehandlung (z.b. Kühlung) erforderlich ist, um optimale Ergebnisse zu erhalten. Da hier nicht alle Parameter
Themeneinheit U Medizinaltechnik 4 Vorbereitung und Assistenz bei diagnostischen und therapeutischen Massnahmen
 Themeneinheit U Medizinaltechnik 4 Vorbereitung und ssistenz bei diagnostischen und therapeutischen Massnahmen 4.2.9 Nachsorge bei Injektionen Die Entsorgung des gebrauchten Materials findet direkt im
Themeneinheit U Medizinaltechnik 4 Vorbereitung und ssistenz bei diagnostischen und therapeutischen Massnahmen 4.2.9 Nachsorge bei Injektionen Die Entsorgung des gebrauchten Materials findet direkt im
9 x in Wien. Blutabnahme. Workshop mit Übungen für ArztassistentInnen. Univ. Doz. Georg Endler & Sonja Meyer
 Blutabnahme Workshop mit Übungen für ArztassistentInnen Univ. Doz. Georg Endler & Sonja Meyer Die nächsten 60 Minuten Rechtliche Grundlagen Präanalytik Welches Röhrchen wofür? Technische Durchführung Häufige
Blutabnahme Workshop mit Übungen für ArztassistentInnen Univ. Doz. Georg Endler & Sonja Meyer Die nächsten 60 Minuten Rechtliche Grundlagen Präanalytik Welches Röhrchen wofür? Technische Durchführung Häufige
Praxis der Blutentnahme. Marc Deschka. Ein Leitfaden für medizinisches Fachpersonal
 Marc Deschka Praxis der Blutentnahme Ein Leitfaden für medizinisches Fachpersonal Einfache und sichere Gewinnung von Kapillar- und Venenblut in der ambulanten und stationären Patientenversorgung Der Autor
Marc Deschka Praxis der Blutentnahme Ein Leitfaden für medizinisches Fachpersonal Einfache und sichere Gewinnung von Kapillar- und Venenblut in der ambulanten und stationären Patientenversorgung Der Autor
Ernährung Das Blut trägt die zum Stoffwechsel notwendigen Nährstoffe an die Gewerbezellen heran.
 Blutbild des Hundes Blutbilder sagen aus ob ein Hund gesund ist oder nicht. Dennoch kann man sich nicht alleine auf die Blutwerte verlassen. Das äußere Erscheinungsbild und Verhalten des Hundes Muss immer
Blutbild des Hundes Blutbilder sagen aus ob ein Hund gesund ist oder nicht. Dennoch kann man sich nicht alleine auf die Blutwerte verlassen. Das äußere Erscheinungsbild und Verhalten des Hundes Muss immer
Hinweise zur Präanalytik
 Hinweise zur Präanalytik MZLA Versorgungszentrum GmbH 04600 Altenburg Am Waldessaum 10 Version B vom 07.02.13 Seite 1/17 Inhalt 1. Allgemeines... 3 1.1 Grundlagen... 3 1.2 Abrechnung... 3 2. Verantwortlichkeiten...
Hinweise zur Präanalytik MZLA Versorgungszentrum GmbH 04600 Altenburg Am Waldessaum 10 Version B vom 07.02.13 Seite 1/17 Inhalt 1. Allgemeines... 3 1.1 Grundlagen... 3 1.2 Abrechnung... 3 2. Verantwortlichkeiten...
Schulungsunterlagen Zentrallabor
 Schulungsunterlagen Zentrallabor Institut für Klinische Chemie & Pharmakologie Zentrallabor Dr. med. Andreas Grigull Stand 10.02.2010 Lauris ist ein System zur elektronischen Anforderung von Laborbefunden.
Schulungsunterlagen Zentrallabor Institut für Klinische Chemie & Pharmakologie Zentrallabor Dr. med. Andreas Grigull Stand 10.02.2010 Lauris ist ein System zur elektronischen Anforderung von Laborbefunden.
Labor und apparative Diagnostik. kompakt-information. detail-information. 6.1 Labor. 6.2 Infektionsdiagnostik. 6.3 Befunde aus apparativer Diagnostik
 Labor und apparative Diagnostik kompakt-information detail-information 6.1 Labor 6.2 Infektionsdiagnostik 6.3 Befunde aus apparativer Diagnostik Labor und apparative Diagnostik kompakt Untersuchungen klären
Labor und apparative Diagnostik kompakt-information detail-information 6.1 Labor 6.2 Infektionsdiagnostik 6.3 Befunde aus apparativer Diagnostik Labor und apparative Diagnostik kompakt Untersuchungen klären
Materialanforderungen / Probenvorbereitung PRÄANALYTIK. Spezielle Materialerfordernisse (spezielle Bereiche); detaillierte Angaben einzelne Parameter
Materialanforderungen / Probenvorbereitung PRÄANALYTIK Spezielle Materialerfordernisse (spezielle Bereiche); detaillierte Angaben einzelne Parameter Angegebene Mengen sind für Einzelanalysen berechnet.
Materialanforderungen / Probenvorbereitung PRÄANALYTIK Spezielle Materialerfordernisse (spezielle Bereiche); detaillierte Angaben einzelne Parameter Angegebene Mengen sind für Einzelanalysen berechnet.
Präanalytik. Die 11 häufigsten Fehler in der Präanalytik:
 Präanalytik Unter Präanalytik werden alle Prozesse zusammengefasst, die vor der eigentlichen Laboranalyse ablaufen, im einzelnen Probengewinnung Transport und Lagerung Vorbereitung des Untersuchungs- /
Präanalytik Unter Präanalytik werden alle Prozesse zusammengefasst, die vor der eigentlichen Laboranalyse ablaufen, im einzelnen Probengewinnung Transport und Lagerung Vorbereitung des Untersuchungs- /
Crash-Kurs Klin. Chemie und Laboratoriumsmedizin 2. Teil: Spektrum und Materialgewinnung
 Marburg, den 26.10.2004 Crash-Kurs Klin. Chemie und Laboratoriumsmedizin 2. Teil: Spektrum und Materialgewinnung Prakt.. Übung: Gegenseitige Blutentnahme Verantwortlicher Leiter: Prof. Dr. Harald Renz
Marburg, den 26.10.2004 Crash-Kurs Klin. Chemie und Laboratoriumsmedizin 2. Teil: Spektrum und Materialgewinnung Prakt.. Übung: Gegenseitige Blutentnahme Verantwortlicher Leiter: Prof. Dr. Harald Renz
Fachbereich: Liquoranalytik. Änderungen: Quellenangabe für Referenzbereich Liquor-Laktat. A4 F Rev. 2 / Freigegeben -
 Freigegeben Seite 1 von 6 Stand: 28.02.2013 Bearbeiter: J. Böhm Fachbereich: Liquoranalytik Änderungen: Quellenangabe für LiquorLaktat erhöhte Werte niedrige Werte P:\13_zentrallabor\publickataloge\flklq
Freigegeben Seite 1 von 6 Stand: 28.02.2013 Bearbeiter: J. Böhm Fachbereich: Liquoranalytik Änderungen: Quellenangabe für LiquorLaktat erhöhte Werte niedrige Werte P:\13_zentrallabor\publickataloge\flklq
Zweifel am Laborbefund?
 Zweifel am Laborbefund? Plausibilitätskontrolle Werte passen nicht Laborfehler Welche Faktoren beeinflussen Laborwerte vor der Analyse? Präanalytik und Störfaktoren Wie sicher analysiert das Labor? Qualitätsmanagement
Zweifel am Laborbefund? Plausibilitätskontrolle Werte passen nicht Laborfehler Welche Faktoren beeinflussen Laborwerte vor der Analyse? Präanalytik und Störfaktoren Wie sicher analysiert das Labor? Qualitätsmanagement
Organisation eines Studiensekretariates
 Organisation eines Studiensekretariates Dipl. Kffr. Claudia Nordt Klinik und Poliklinik für Frauenheilkunde und Geburtshilfe Übersicht Neue Studie Neue Patientin Im Verlauf einer Studie Dokumentation Follow
Organisation eines Studiensekretariates Dipl. Kffr. Claudia Nordt Klinik und Poliklinik für Frauenheilkunde und Geburtshilfe Übersicht Neue Studie Neue Patientin Im Verlauf einer Studie Dokumentation Follow
Zusammenfassung: Bilirubin
 Zusammenfassung: Bilirubin 1. Setzen Sie richtig ein: Lipophil, wasserlöslich, wasserunlöslich, mit Glucuronsäure konjugiert, konjugiertes Bilirubin, unkonjugiertes Bilirubin, an Albumin gebunden, kann
Zusammenfassung: Bilirubin 1. Setzen Sie richtig ein: Lipophil, wasserlöslich, wasserunlöslich, mit Glucuronsäure konjugiert, konjugiertes Bilirubin, unkonjugiertes Bilirubin, an Albumin gebunden, kann
piccolo Analyzer Kurzbedienungsanleitung Leitfaden zur Probengewinnung Zur umfassenden Information benutzen Sie bitte das piccolo Bedienerhandbuch
 Kurzbedienungsanleitung Leitfaden zur Probengewinnung Zur umfassenden Information benutzen Sie bitte das piccolo Bedienerhandbuch Abaxis, Inc. 3240 Whipple Road Union City, CA 94587 TESTDURCHFUEHRUNG MIT
Kurzbedienungsanleitung Leitfaden zur Probengewinnung Zur umfassenden Information benutzen Sie bitte das piccolo Bedienerhandbuch Abaxis, Inc. 3240 Whipple Road Union City, CA 94587 TESTDURCHFUEHRUNG MIT
Allgemeines Krankenhaus der Stadt Wien Medizinischer Universitätscampus 1090 Wien, Währinger Gürtel 18-20
 Dr. Robert Pinter Zollhausstraße 6 7022 Schattendorf Univ. Klinik für Innere Medizin III Klin. Abteilung für Nephrologie und Dialyse Leitung: Univ.Prof. Dr. Rainer Oberbauer Nierentransplantambulanz PatientInneninformation
Dr. Robert Pinter Zollhausstraße 6 7022 Schattendorf Univ. Klinik für Innere Medizin III Klin. Abteilung für Nephrologie und Dialyse Leitung: Univ.Prof. Dr. Rainer Oberbauer Nierentransplantambulanz PatientInneninformation
Anleitung zur Probenentnahme
 Patienten - INFO Anleitung zur Probenentnahme Blut-, Stuhl-, Urin- und Speichelentnahme Sehr geehrte Patientin, sehr geehrter Patient, die Qualität labormedizinischer Diagnostik hängt maßgeblich von der
Patienten - INFO Anleitung zur Probenentnahme Blut-, Stuhl-, Urin- und Speichelentnahme Sehr geehrte Patientin, sehr geehrter Patient, die Qualität labormedizinischer Diagnostik hängt maßgeblich von der
Liste der Referenzbereiche QML 027
 Seite 1 von 16 A1-MICRO a1-microglobulin im Urin < 12 mg/l 2; S.113 AFP a1-fetoprotein bis 10 Monate sehr hohe Werte (Text beachten) ( Test: ECLIA Roche ) ab 10.Monat- Erwachsene < 10 µg/l 1; Bd.2, S.1619
Seite 1 von 16 A1-MICRO a1-microglobulin im Urin < 12 mg/l 2; S.113 AFP a1-fetoprotein bis 10 Monate sehr hohe Werte (Text beachten) ( Test: ECLIA Roche ) ab 10.Monat- Erwachsene < 10 µg/l 1; Bd.2, S.1619
MVZ Labor Bochum MLB GmbH
 Herr Dr. med. Musiol (0234) 9 70 67-220 Herr Prof. Dr. med. Schmidt Frau Stahlschmidt Technische Laborleitung: Frau Bühne / Frau Voigt (0234) 9 70 67-220 Herr Dr. rer. nat. Menzel (Mikrobiologie) (0234)
Herr Dr. med. Musiol (0234) 9 70 67-220 Herr Prof. Dr. med. Schmidt Frau Stahlschmidt Technische Laborleitung: Frau Bühne / Frau Voigt (0234) 9 70 67-220 Herr Dr. rer. nat. Menzel (Mikrobiologie) (0234)
Laborparameter sind Hilfsproben
 Probleme im Milchviehbestand Hilft eine Blutuntersuchung weiter? Dr. M. Höltershinken Klinik für Rinder Stiftung Tierärztliche Hochschule Hannover HANSA-Landhandel Rinderfachtagung 2013 29.Oktoberr 2013
Probleme im Milchviehbestand Hilft eine Blutuntersuchung weiter? Dr. M. Höltershinken Klinik für Rinder Stiftung Tierärztliche Hochschule Hannover HANSA-Landhandel Rinderfachtagung 2013 29.Oktoberr 2013
Kapitel 2.2 Kardiopulmonale Homöostase. Kohlendioxid
 Kapitel 2.2 Kardiopulmonale Homöostase Kohlendioxid Transport im Plasma Bei der Bildung von im Stoffwechsel ist sein Partialdruck höher als im Blut, diffundiert folglich ins Plasmawasser und löst sich
Kapitel 2.2 Kardiopulmonale Homöostase Kohlendioxid Transport im Plasma Bei der Bildung von im Stoffwechsel ist sein Partialdruck höher als im Blut, diffundiert folglich ins Plasmawasser und löst sich
Allgemeines Kontakte Ablauf einer Laboruntersuchung... 3
 Inhalt Allgemeines... 1 Kontakte... 2 Ablauf einer Laboruntersuchung... 3 Präanalytik... 4 Patientenbezogene Einflussfaktoren... 5 Sonstige Einflussfaktoren... 5 Die korrekte Laboranforderung... 6 Allgemein...
Inhalt Allgemeines... 1 Kontakte... 2 Ablauf einer Laboruntersuchung... 3 Präanalytik... 4 Patientenbezogene Einflussfaktoren... 5 Sonstige Einflussfaktoren... 5 Die korrekte Laboranforderung... 6 Allgemein...
Validität von Laborbefunden: Präanalytik und Störfaktoren
 Literaturhinweise Renz H; Praktische Labordiagnostik, Verlag de Gruyter, Kapitel 17 Dörner K; Klinische Chemie und Hämatologie, Verlag Thieme, Kapitel 1.1 Neumeister B, Besenthal I, Böhm BO; Klinikleitfaden
Literaturhinweise Renz H; Praktische Labordiagnostik, Verlag de Gruyter, Kapitel 17 Dörner K; Klinische Chemie und Hämatologie, Verlag Thieme, Kapitel 1.1 Neumeister B, Besenthal I, Böhm BO; Klinikleitfaden
Massgeschneiderte Dienstleistungen
 Massgeschneiderte Dienstleistungen Blutspendedienst SRK Bern AG kompetenter Partner der Life Science Industrie für Blutprodukte und labordiagnostische Analysen. 2 Über uns Im Rahmen seiner Kernaufgabe
Massgeschneiderte Dienstleistungen Blutspendedienst SRK Bern AG kompetenter Partner der Life Science Industrie für Blutprodukte und labordiagnostische Analysen. 2 Über uns Im Rahmen seiner Kernaufgabe
Was gehört ins Praxislabor?
 12. Fortbildungstagung des KHM, Luzern Roman Fried, Adliswil / Jürg Rufener, Interlaken Verein für med. Qualitätkontrolle, Zürich Qualitätskontrollzentrum im IKC/USZ Ringversuche für 3600 Teilnehmer Klin.
12. Fortbildungstagung des KHM, Luzern Roman Fried, Adliswil / Jürg Rufener, Interlaken Verein für med. Qualitätkontrolle, Zürich Qualitätskontrollzentrum im IKC/USZ Ringversuche für 3600 Teilnehmer Klin.
Merkblatt zur Einsendung von Proben EXTERN
 1/6 Merkblatt zur Einsendung von Proben EXTERN Liebe Kollegin, lieber Kollege! Qualitativ hochwertige, aussagekräftige Laborbefunde können nur aus einwandfreiem Probenmaterial gewonnen werden. Probenentnahme
1/6 Merkblatt zur Einsendung von Proben EXTERN Liebe Kollegin, lieber Kollege! Qualitativ hochwertige, aussagekräftige Laborbefunde können nur aus einwandfreiem Probenmaterial gewonnen werden. Probenentnahme
Untersuchungsangebot des Kinderhämatologischen Labors der Klinik für Kinder- und Jugendmedizin des Universitätsklinikums Heidelberg
 Untersuchungsangebot des Kinderhämatologischen Labors der Klinik für Kinder- und Jugendmedizin des Universitätsklinikums Heidelberg Untersuchungsmaterial Referenzbereiche Stand: Dezember 2012 Seite 1 von
Untersuchungsangebot des Kinderhämatologischen Labors der Klinik für Kinder- und Jugendmedizin des Universitätsklinikums Heidelberg Untersuchungsmaterial Referenzbereiche Stand: Dezember 2012 Seite 1 von
Seminar: Blutgasanalytik
 Seminar: Blutgasanalytik Dr. med. Bernhard Schlüter Centrum für Laboratoriumsmedizin - Zentrallaboratorium - Universitätsklinikum Münster Wintersemester 2015/16 Gliederung 1. Anwendungen der Blutgasanalytik
Seminar: Blutgasanalytik Dr. med. Bernhard Schlüter Centrum für Laboratoriumsmedizin - Zentrallaboratorium - Universitätsklinikum Münster Wintersemester 2015/16 Gliederung 1. Anwendungen der Blutgasanalytik
Klinische Chemie. Dr. Th. Eller (EurClinChem) MHA Leiter der Geschäftstelle
 Klinische Chemie Dr. Th. Eller (EurClinChem) MHA Leiter der Geschäftstelle Einführung in die Klinische Chemie Klinische Chemie ist analytische Biochemie unter erschwerten Bedingungen. (Prof. Dr. Dr. S.
Klinische Chemie Dr. Th. Eller (EurClinChem) MHA Leiter der Geschäftstelle Einführung in die Klinische Chemie Klinische Chemie ist analytische Biochemie unter erschwerten Bedingungen. (Prof. Dr. Dr. S.
DRK-Blutspendedienst Baden-Württemberg Hessen gemeinnützige GmbH Institut Baden-Baden. Institut für Transfusionsmedizin Baden-Baden gemeinnützige GmbH
 DRK-Blutspendedienst Baden-Württemberg Hessen gemeinnützige GmbH Institut Baden-Baden Institut für Transfusionsmedizin Baden-Baden gemeinnützige GmbH Laborpraxis im DRK-Blutspendedienst Baden-Baden Laborleistungen
DRK-Blutspendedienst Baden-Württemberg Hessen gemeinnützige GmbH Institut Baden-Baden Institut für Transfusionsmedizin Baden-Baden gemeinnützige GmbH Laborpraxis im DRK-Blutspendedienst Baden-Baden Laborleistungen
Herzlich Willkommen!
 Herzlich Willkommen! Standardisierte Blut-, Harn- und Stuhluntersuchungen in der Arztpraxis (Point-of-care-Testing) Georg Endler Labors.at Sonja Meyer Ordibed GmbH www.ordibed.at Hilfe ich werde von der
Herzlich Willkommen! Standardisierte Blut-, Harn- und Stuhluntersuchungen in der Arztpraxis (Point-of-care-Testing) Georg Endler Labors.at Sonja Meyer Ordibed GmbH www.ordibed.at Hilfe ich werde von der
Anforderung von Laborleistungen
 Seite 1 von 11 von Untersuchungsmaterial Verfasser: Prüfer: Freigabe: 01.09.15 Christiane Külper 07.09.15 Dr. rer. medic. Uta Oelschlägel 09.09.15 Dr. rer. medic. Brigitte Mohr 18.09.15 Prof. Dr. med.
Seite 1 von 11 von Untersuchungsmaterial Verfasser: Prüfer: Freigabe: 01.09.15 Christiane Külper 07.09.15 Dr. rer. medic. Uta Oelschlägel 09.09.15 Dr. rer. medic. Brigitte Mohr 18.09.15 Prof. Dr. med.
cobas c 111 Analyzer Das kompakte System für die klinische Chemie
 cobas c 111 Analyzer Das kompakte System für die klinische Chemie Lösungen für den Serumarbeitsplatz Laboratorien stehen heute vor der Herausforderung, mit geringeren Ressourcen hohen Laborleistungsstandards
cobas c 111 Analyzer Das kompakte System für die klinische Chemie Lösungen für den Serumarbeitsplatz Laboratorien stehen heute vor der Herausforderung, mit geringeren Ressourcen hohen Laborleistungsstandards
Aufgaben der Leber. Lies den Text zur Leber und mache dir Notizen. Versuche heraus zu finden, was gespeichert, umgewandelt und abgebaut wird.
 Aufgaben der Leber Lies den Text zur Leber und mache dir Notizen. Versuche heraus zu finden, was gespeichert, umgewandelt und abgebaut wird. Das Zentrallabor der Körpers Die Leber baut auf: - Glykogen,
Aufgaben der Leber Lies den Text zur Leber und mache dir Notizen. Versuche heraus zu finden, was gespeichert, umgewandelt und abgebaut wird. Das Zentrallabor der Körpers Die Leber baut auf: - Glykogen,
Anleitung zum Ringversuch MQ 2013-1
 Verein für medizinische Qualitätskontrolle Association pour le contrôle de Qualité médical Associazione per il controllo di qualità medico Anleitung zum Ringversuch MQ 2013-1 Neu: K33, A1cNow: Teilnehmer
Verein für medizinische Qualitätskontrolle Association pour le contrôle de Qualité médical Associazione per il controllo di qualità medico Anleitung zum Ringversuch MQ 2013-1 Neu: K33, A1cNow: Teilnehmer
Analysen-Spektrum MEDILYS. Enzyme, Substrate, Elektrolyte. Funktionsteste. Amylase, Pankreas AP. Laktat Laktat i.l.
 Enzyme, Substrate, Elektrolyte ACE Alkohol Aminolävulinsäure Ammoniak Amylase Pankreas i.u. Amylase, Pankreas AP BGA Bilirubin Bilirubin direkt Bilirubin neonat. Calcium Calcium i.u. CHE Chlorid Chlorid
Enzyme, Substrate, Elektrolyte ACE Alkohol Aminolävulinsäure Ammoniak Amylase Pankreas i.u. Amylase, Pankreas AP BGA Bilirubin Bilirubin direkt Bilirubin neonat. Calcium Calcium i.u. CHE Chlorid Chlorid
Werte für Menschen, Tiere und Umwelt. synlab Präanalytik. Auszug aus der Akademieinfo
 Werte für Menschen, Tiere und Umwelt synlab Präanalytik Auszug aus der Akademieinfo Inhalt Vorwort 3 1 Blutuntersuchungen 4 Was will ich wissen? 4 Einflussgrößen sind in vivo-prozesse 4 Störgrößen sind
Werte für Menschen, Tiere und Umwelt synlab Präanalytik Auszug aus der Akademieinfo Inhalt Vorwort 3 1 Blutuntersuchungen 4 Was will ich wissen? 4 Einflussgrößen sind in vivo-prozesse 4 Störgrößen sind
INHALTSVERZEICHNIS. Stand: 11.04.2013
 INHALTSVERZEICHNIS 1. Laboratorien Organisatorisches Ansprechpartner 1.1.Gesellschafter 1.2. Postanschrift 1.3. Probenannahme im Labor 1.4. Telefonübersicht 1.5. Untersuchungen in Fremdlaboratorien (externe
INHALTSVERZEICHNIS 1. Laboratorien Organisatorisches Ansprechpartner 1.1.Gesellschafter 1.2. Postanschrift 1.3. Probenannahme im Labor 1.4. Telefonübersicht 1.5. Untersuchungen in Fremdlaboratorien (externe
Blutanalysen durchführen dort wo sie benötigt werden ohne Wartezeit, ohne Probenaufbereitung, ohne zusätzliche Logistik
 Point-of-Care Analyse System für Klinische Chemie und Elektrolyte Point - of-care Analysesystem für Klinische Chemie und Elektrolyte piccolo ist das Blutanalyse-System zur Bestimmung der Klinischen Chemie
Point-of-Care Analyse System für Klinische Chemie und Elektrolyte Point - of-care Analysesystem für Klinische Chemie und Elektrolyte piccolo ist das Blutanalyse-System zur Bestimmung der Klinischen Chemie
Seminar Leber / Ikterus
 Seminar Leber / Ikterus Wintersemester 2016 / 2017 Universitätsklinikum Düsseldorf Institut für Laboratoriumsdiagnostik / Zentrallabor Fall 1: Ikterischer Patient, 28 Jahre alt Anamnese: Patient ist seit
Seminar Leber / Ikterus Wintersemester 2016 / 2017 Universitätsklinikum Düsseldorf Institut für Laboratoriumsdiagnostik / Zentrallabor Fall 1: Ikterischer Patient, 28 Jahre alt Anamnese: Patient ist seit
Was hätten Sie gemacht?
 Der spannende Ernährungsfall oder die Frage: Was hätten Sie gemacht? Bergisch Gladbach, den 9. November 2016 Dr. Rolf Schaefer Mittwoch Mittag, Anruf aus der chirurgischen Ambulanz: Chirurg: Ich habe hier
Der spannende Ernährungsfall oder die Frage: Was hätten Sie gemacht? Bergisch Gladbach, den 9. November 2016 Dr. Rolf Schaefer Mittwoch Mittag, Anruf aus der chirurgischen Ambulanz: Chirurg: Ich habe hier
Laborkatalog. Albumin 37,0-59,0 g/l Serum R1 Chemisch oder Elektophorese. Punktate R2 im Profil
 Seite 1 / 8 A ACTH 9-52 pg/ml EDTA auf Eis NUK 1 basal und Tagesprofil Addis Count Sammelurin 180 min. R1 Adenovirus Ak IgG,IgA,KBR Serum ZINSTKo Mikrobio. ZINST M. Albumin 37,0-59,0 g/l Serum R1 Chemisch
Seite 1 / 8 A ACTH 9-52 pg/ml EDTA auf Eis NUK 1 basal und Tagesprofil Addis Count Sammelurin 180 min. R1 Adenovirus Ak IgG,IgA,KBR Serum ZINSTKo Mikrobio. ZINST M. Albumin 37,0-59,0 g/l Serum R1 Chemisch
8 Laboraufträge und Probennahme
 8 Laboraufträge und Probennahme 8.1 Laboraufträge Die Auftragserteilung erfolgt mittels Auftragsformularen (siehe Kap. 8.1.2). Deren Inhalt wird regelmässig auf ihre Zweckmässigkeit überprüft und bei Bedarf
8 Laboraufträge und Probennahme 8.1 Laboraufträge Die Auftragserteilung erfolgt mittels Auftragsformularen (siehe Kap. 8.1.2). Deren Inhalt wird regelmässig auf ihre Zweckmässigkeit überprüft und bei Bedarf
Produktkatalog. BD Diagnostics Preanalytical Systems
 Produktkatalog BD Diagnostics Preanalytical Systems Ihre Ansprechpartner im Kundendienst Deutschland: Telefon: 0 0 und 0 0 9 Fax: 0 0 0 Email: [email protected] Österreich: Telefon:
Produktkatalog BD Diagnostics Preanalytical Systems Ihre Ansprechpartner im Kundendienst Deutschland: Telefon: 0 0 und 0 0 9 Fax: 0 0 0 Email: [email protected] Österreich: Telefon:
Handbuch der Präanalytik
 Ein praktischer Leitfaden für die Probengewinnung und Einsendung Laborjournal Augsburg Labor Schottdorf MVZ GmbH Bochum MVZ Labor Bochum MLB GmbH Hamburg Labor Hamburg-Lübeck MVZ GmbH Hannover Labor Hannover
Ein praktischer Leitfaden für die Probengewinnung und Einsendung Laborjournal Augsburg Labor Schottdorf MVZ GmbH Bochum MVZ Labor Bochum MLB GmbH Hamburg Labor Hamburg-Lübeck MVZ GmbH Hannover Labor Hannover
Regionale Citratantikoagulation in der kontinuierlichen Nierenersatztherapie
 1 Regionale Citratantikoagulation in der kontinuierlichen Nierenersatztherapie Torsten Slowinski Universitätsklinikum Charité Campus Mitte Klinik für Nephrologie Berlin 2 KDIGO (2012): Empfehlung zur Antikoagulation
1 Regionale Citratantikoagulation in der kontinuierlichen Nierenersatztherapie Torsten Slowinski Universitätsklinikum Charité Campus Mitte Klinik für Nephrologie Berlin 2 KDIGO (2012): Empfehlung zur Antikoagulation
@ Internet. Nutzungshinweise. Suchen. Lesezeichen. Hilfsmittel. Stichwortverzeichnis. Bestellnummernübersicht. Sarstedt.
 2006/2007 2006/2007 Nutzungshinweise Navigation Lesezeichen Hinweise Suchen Der Sarstedt-Gesamtkatalog ist mittels Lesezeichen in Produktgruppen unterteilt. Alle Produktgruppen können unter Verwendung
2006/2007 2006/2007 Nutzungshinweise Navigation Lesezeichen Hinweise Suchen Der Sarstedt-Gesamtkatalog ist mittels Lesezeichen in Produktgruppen unterteilt. Alle Produktgruppen können unter Verwendung
Blutentnahmesystem. Handhabungsempfehlungen.
 Blutentnahmesystem Handhabungsempfehlungen Inhalt Vorwort Vorwort... Vorbereitung der Blutentnahme... Auswahl der Punktionsstelle... Venenpunktion... Empfohlene Reihenfolge der Blutentnahmeröhrchen...
Blutentnahmesystem Handhabungsempfehlungen Inhalt Vorwort Vorwort... Vorbereitung der Blutentnahme... Auswahl der Punktionsstelle... Venenpunktion... Empfohlene Reihenfolge der Blutentnahmeröhrchen...
